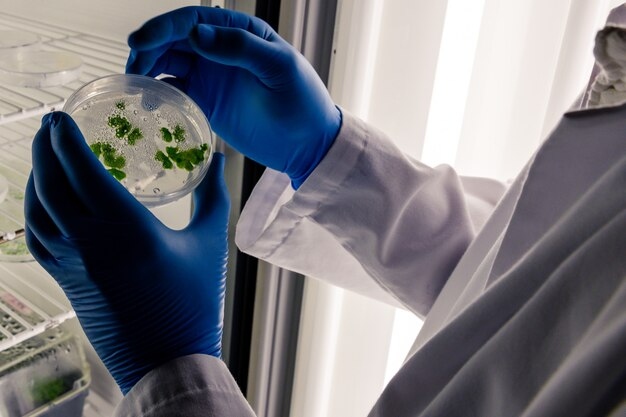

70대할머니선물 무엇으로 할까 고민될 때, 지수씨 3종 세트
2025.10.01

안녕하세요^^ 연말이 이제 슬슬 다가오면서 주변 사람들에게 선물을 하기 위한 선물용품을 많이 찾게 되는 ...
출처
https://blog.naver.com/liasalang/223630686659
이슈모어 핫이슈
-
 영화 눈동자 신민아 첫 1인 2역 도전…시력을 잃어가는 사진작가의 숨겨진 진실 추적
영화 눈동자가 배우 신민아의 새로운 변신으로 관심을 받고 있다. 그동안 로맨스와 휴먼 장르에서 많은 사랑을 …
영화 눈동자 신민아 첫 1인 2역 도전…시력을 잃어가는 사진작가의 숨겨진 진실 추적
영화 눈동자가 배우 신민아의 새로운 변신으로 관심을 받고 있다. 그동안 로맨스와 휴먼 장르에서 많은 사랑을 …
-
 허가윤 근황 공개, 포미닛 이후 발리에서 찾은 가장 다른 행복
허가윤 근황이 다시 관심을 받고 있다. 그룹 포미닛 출신 허가윤은 최근 한국에서 보낸 시간을 돌아보며 발리 …
허가윤 근황 공개, 포미닛 이후 발리에서 찾은 가장 다른 행복
허가윤 근황이 다시 관심을 받고 있다. 그룹 포미닛 출신 허가윤은 최근 한국에서 보낸 시간을 돌아보며 발리 …
-
 이승기 콘서트 13년 기다림 끝난다, 기승전 락으로 다시 증명할 가수의 시간
이승기 콘서트 소식이 공개되며 오랜 시간 그의 음악 무대를 기다려온 팬들의 관심이 집중되고 있다. 가수 겸 …
이승기 콘서트 13년 기다림 끝난다, 기승전 락으로 다시 증명할 가수의 시간
이승기 콘서트 소식이 공개되며 오랜 시간 그의 음악 무대를 기다려온 팬들의 관심이 집중되고 있다. 가수 겸 …
관련 포스팅
Copyright blog.dowoo.me All right reserved.